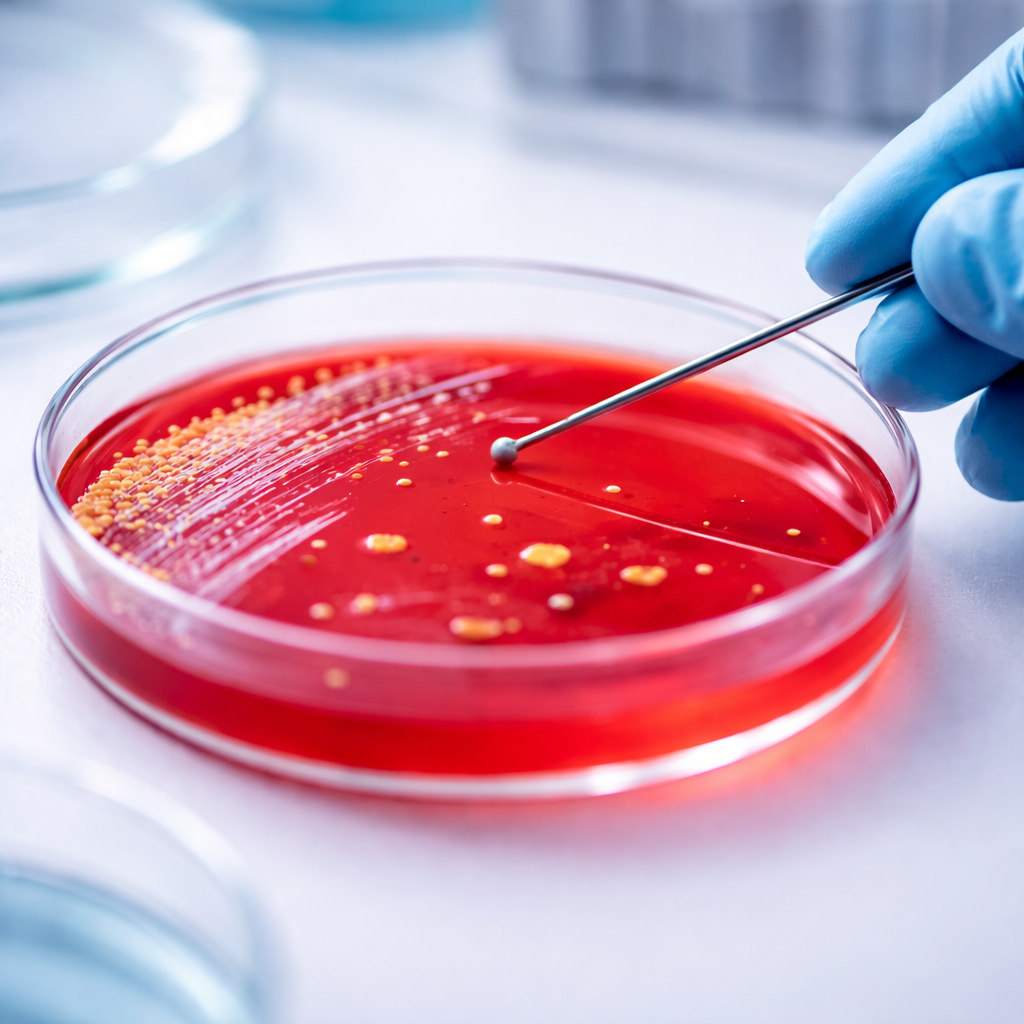
Petrischale mit rotem Nährmedium, auf dem Mikroorganismen im Labor mit einer Impföse untersucht werden.

Spermaspuren Nachweisen
Besteht in Ihrer Beziehung ein quälender Verdacht auf Untreue? Oft sind es kleine Indizien, die das Vertrauen erschüttern. In solchen Momenten ist professionelle Klarheit der einzige Weg, um die eigene Handlungsfähigkeit zurückzugewinnen. Wir bieten Ihnen spezialisierte forensische Analysen zum Nachweis von Spermaspuren an – diskret, sicher und hochpräzise.
Warum ein professioneller Spermanachweis?
Häusliche Tests aus dem Internet oder der Apotheke sind für diesen Anwendungsbereich nicht geeignet, auch nicht zur ersten Orientierung bei der Feststellung möglicher Fremdspuren. Ihre Ergebnisse hängen stark von der Anwendung ab und basieren auf medizinischen Testverfahren, die nicht mit kriminalbiologischen Fragestellungen vergleichbar sind. Ein PSA-Test aus der Apotheke unterscheidet sich grundlegend von einer professionell durchgeführten forensischen Analyse. Untersuchungen nach kriminalbiologischen Standards, wie sie bei Forensik Leutz durchgeführt werden, sind speziell auf die sichere Identifikation und Bewertung relevanter Spuren ausgelegt und bieten eine entsprechend belastbare Grundlage.
Wie funktioniert die Probenahme?
- Sicherung der Textilien
Berühren Sie verdächtige Stellen möglichst nicht mit bloßen Händen (Einweghandschuhe verwenden).
- Trockene Lagerung
Verpacken Sie die Proben in Papiertüten, niemals in Plastikbeuteln, da Feuchtigkeit die biologischen Spuren zerstören kann.
- Versand
Senden Sie uns das Material in einem neutralen Umschlag zu.
Unsere Leistungen im Überblick
- Identifikation von Körperflüssigkeiten
Wir prüfen Proben (Wäsche, Probenahme-Sticks) auf das Vorhandensein von saurer Phosphatase und prostataspezifischem Antigen (PSA).
- Mikroskopische Analyse
Direkter Nachweis von Spermien zur absoluten Absicherung des Befundes.
- DNA-Extraktion (Optional):
Falls gewünscht, kann im Anschluss ein DNA-Profil erstellt werden, um die Spuren einer bestimmten Person zuzuordnen oder Fremd-DNA auszuschließen.
- Höchste Diskretion
Der Versand der Proben und die Ergebnismitteilung erfolgen absolut vertraulich und anonymisiert.
Probleme, Zweifel, Sorgen? Wir helfen Ihnen!
Wie alt dürfen die Spuren sein?
Eingetrocknetes Sperma kann deutlich länger nachgewiesen werden als angenommen. Bei trockener und geeigneter Lagerung von Textilien ist ein forensischer Nachweis nicht nur nach Wochen oder Monaten möglich, sondern sogar nach Jahren. In der Forensik wurden bereits Spermaspuren identifiziert, die bis zu 30 Jahre alt waren.
Kann man Sperma nach der Wäsche nachweisen?
Auch nach einem intensiven Waschgang mit Bleichmitteln kann ein Nachweis unter bestimmten Umständen weiterhin möglich sein, wenngleich die Chancen deutlich reduziert sind, bei Fragen steht Ihnen der Forensiker Holger Leutz gerne zur Verfügung.
Ist das Ergebnis gerichtsverwertbar?
Eine gerichtliche Verwertbarkeit von DNA-Analysen wird in der Regel ausschließlich durch Gerichtsmediziner oder staatliche Stellen wie das BKA durchgeführt. Diese Untersuchungen können von Privatpersonen jedoch nicht direkt beauftragt werden. Holger Leutz bietet mit seinen Analysen die Schließung dieser Lücke an, indem Tests auf vergleichbarem forensischem Niveau durchgeführt werden, um eine fundierte und belastbare Grundlage zu schaffen.
